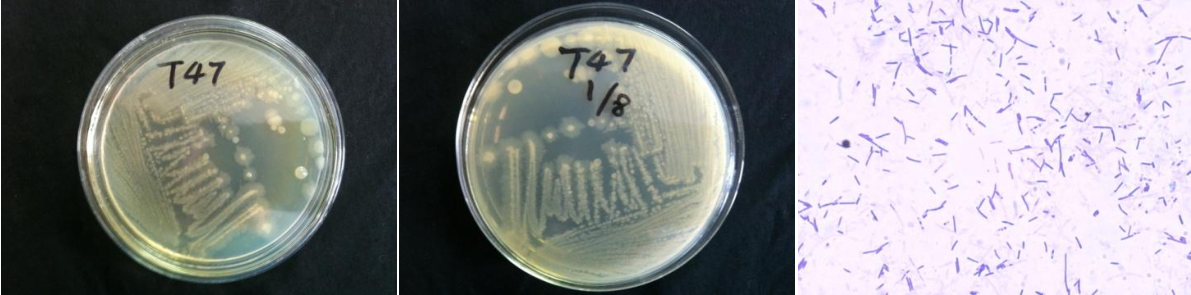

Loading...
| StrainNO | B379 |
| Classification | Brevundimonas |
| 16s rDNA sequence | GCCTGGGGCAGCTACACATGCAGTCGAACGAACTCTTCGGAGTTAGTGGCGGACGGGTGAGTAACACGTGGGAACGTGCCTTTTG GTTCGGAATAACTCAGGGAAACTTGTGCTAATACCGAATGTGCCCTTCGGGGGAAAGATTTATCGCCATTAGAGCGGCCCGCGTC TGATTAGCTAGTTGGTGAGGTAAAAGCTCACCAAGGCGACGATCAGTAGCTGGTCTGAGAGGATGACCAGCCACACTGGGACTGA GACACGGCCCAGACTCCTACGGGAGGCAGCAGTGGGGAATCTTGCGCAATGGGCGAAAGCCTGACGCAGCCATGCCGCGTGAATG ATGAAGGTCTTAGGATTGTAAAATTCTTTCACCGGGGACGATAATGACGGTACCCGGAGAAGAAGCCCCGGCTAACTTCGTGCCA GCAGCCGCGGTAATACGAAGGGGGCTAGCGTTGCTCGGAATTACTGGGCGTAAAGGGCGCGTAGGCGGATCGTTAAGTCAGAGGT GAAATCCCAGGGCTCAACCCTGGAACTGCCTTTGATACTGGCGATCTTGAGTATGAGAGAGGTATGTGGAACTCCGAGTGTAGAG GTGAAATTCGTAGATATTCGGAAGAACACCAGTGGCGAAGGCGACATACTGGCTCATTACTGACGCTGAGGCGCGAAAGCGTGGG GAGCAAACAGGATTAGATACCCTGGTAGTCCACGCCGTAAACGATGATTGCTAGTTGTCGGGCTGCATGCAGTTCGGTGACGCAG CTAACGCATTAAGCAATCCGCCTGGGGAGTACGGTCGCAAGATTAAAACTCAAAGGAATTGACGGGGGCCCGCACAAGCGGTGGA GCATGTGGTTTAATTCGAAGCAACGCGCAGAACCTTACCACCTTTTGACATGCCTGGACCGCCACGGAGACGTGGCTTTCCCTTC GGGGACTAGGACACAGGTGCTGCATGGCTGTCGTCAGCTCGTGTCGTGAGATGTTGGGTTAAGTCCCGCAACGAGCGCAACCCTC GCCATTAGTTGCCATCATTTAGTTGGGAACTCTAATGGGACTGCCGGTGCTAAGCCGGAGGAAGGTGGGGATGACGTCAAGTCCT CATGGCCCTTACAGGGTGGGCTACACACGTGCTACAATGGCGACTACAGAGGGTTAATCCTTAAAAGTCGTCTCAGTTCGGATTG TCCTCTGCAACTCGAGGGCATGAAGTTGGAATCGCTAGTAATCGCGGATCAGCATGCCGCGGTGAATACGTTCCCGGGCCTTGTA CACACCGCCCGTCACACCATGGGAGTTGGTTCTACCCGAAGGCGGTGCGCTAACCAGCAATGGAGGCAGCCGACCACGTAGTCGC A |
| Strain Morphology Photos | |
| Morphological Description | Colony round;clam white;flat;bright;sticky;edge neatly;Bacteriophage Rod-shaped;having spores;Bud bias |